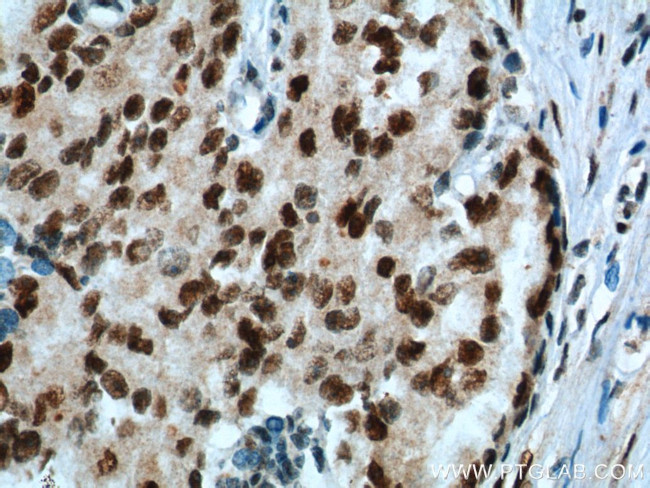
KPNA6 Antibody in Immunohistochemistry (Paraffin) (IHC (P))
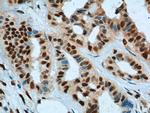
KPNA6 Antibody in Immunohistochemistry (Paraffin) (IHC (P))
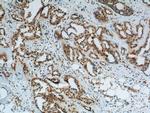
KPNA6 Antibody in Immunohistochemistry (Paraffin) (IHC (P))

Search
Proteintech
KPNA6 Polyclonal Antibody
{{$productOrderCtrl.translations['antibody.pdp.commerceCard.promotion.promotions']}}
{{$productOrderCtrl.translations['antibody.pdp.commerceCard.promotion.viewpromo']}}
{{$productOrderCtrl.translations['antibody.pdp.commerceCard.promotion.promocode']}}: {{promo.promoCode}} {{promo.promoTitle}} {{promo.promoDescription}}. {{$productOrderCtrl.translations['antibody.pdp.commerceCard.promotion.learnmore']}}
产品信息
12366-2-AP
种属反应
宿主/亚型
分类
类型
抗原
偶联物
形式
浓度
规格
纯化类型
保存液
内含物
保存条件
运输条件
产品详细信息
Immunogen sequence: EQAVWALGN IAGDSSVCRD YVLNCSILNP LLTLLTKSTR LTMTRNAVWA LSNLCRGKNP PPEFAKVSPC LPVLSRLLFS SDSDLLADAC WALSYLSDGP NEKIQAVIDS GVCRRLVELL MHNDYKVASP ALRAVGNIVT GDDIQTQVIL NCSALPCLLH LLSSPKESIR KEACWTISNI TAGNRAQIQA VIDANIFPVL IEILQKAEFR TRKEAAWAIT NATSGGTPEQ IRYLVSLGCI KPLCDLLTVM DSKIVQVALN GLENILRLGE QEGKRSGSGV NPYCGLIEEA YGLDKIEFLQ SHENQEIYQK AFDLIEHYFG VEDDDSSLAP QVDETQQQFI FQQPEAPMEG FQL (185-536 aa encoded by BC020520)
靶标信息
Karyopherin, a cytosolic and heterodimeric protein complex consisting of alpha and beta subunits, is responsible for targeting proteins with nuclear localization signals to the nuclear pore complex (NPC) by an energy requiring, Ran-dependent mechanism. The alpha subunit and imported substrate enter the nucleus and accumulate in the nucleoplasm, while the beta subunit accumulates at the NPC. KPNA6 belongs to a subfamily within the KPNA family that also includes IPOA5&6. Down-regulation of KPNA6 by RNAi expression in HeLa cells strongly inhibited cell proliferation, possibly due to blocking the nuclear import of specific factors essential for cell growth and proliferation. KPNA6 also interacts with the Rev protein of HIV-1 and promote its nuclear import.
仅用于科研。不用于诊断过程。未经明确授权不得转售。
生物信息学
蛋白别名: FLJ11249; importin alpha 7 subunit; Importin subunit alpha-7; importin-alpha-S2; karyopherin alpha 6; karyopherin alpha 6 (importin alpha 7); Karyopherin subunit alpha-6; MGC17918; RP4-622L5.1; unnamed protein product
基因别名: IPOA7; KPNA6
UniProt ID: (Human) O60684
Entrez Gene ID: (Human) 23633